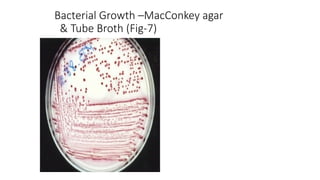
Bacterial Growth –MacConkey agar
& Tube Broth (Fig-7)

The document provides an introduction to bacteriology, detailing the classification, structure, and growth of bacteria, which are unicellular prokaryotic organisms that can be beneficial or pathogenic. It discusses key differences between prokaryotic and eukaryotic cells, bacterial nutrition, and the necessity of various environmental conditions for bacterial growth. Additionally, it covers bacterial reproduction, pathogenicity, and the significance of bacterial cell wall structures for identification and classification.